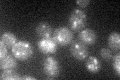
YBR042C
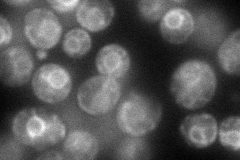
YBR042C
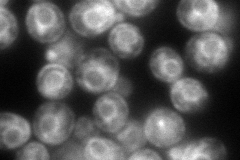
YBR042C
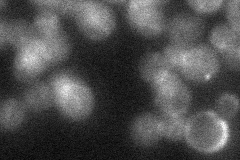
YBR042C
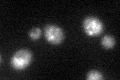
YBR042C
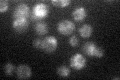
YBR042C

View description
Protein required for incorporation of stearic acid into phosphatidylinositol; affects chromosome stability when overexpressed
Localization:
Intensity:
Fold change:
Significance:
-
C’ GFP library in SD
punctate19.17 -
N' NOP1pr-GFP in SD
ER73.3613 -
N' TEF2pr-mCherry in SD
ER138.487 -
N' NATIVEpr-GFP in SD
ER24.8555 -
N' TEF2pr-VC and Cyto-VN in SD

punctate,vacuole membrane33.0455 -
C’ GFP library in SD+DTT
punctate19.811.03No -
C’ GFP library in SD+H2O2

punctate23.191.2No -
C’ GFP library in Starvation Media
punctate29.391.53No -
C’ GFP library on the background of Pup2-DaMP

punctate -
C’ GFP library on the background of CCT mutant

punctate16.95520.884135No
